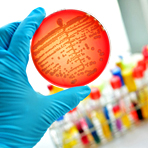

Bei einer wachsenden Zahl von Patienten in Deutschland werden Keime mit Resistenzen gegen wichtige Reserveantibiotika nachgewiesen. Das geht aus Daten des Nationalen Referenzzentrums für gramnegative Krankenhauserreger (NRZ) der Ruhr-Universität Bochum hervor, die das Robert-Koch-Institut in Berlin kürzlich veröffentlichte.
Daten von Patienten mit Verdacht auf Antibiotikaresistenzen zeigen: Im Jahr 2017 fanden sich in fast jeder dritten Probe eine sogenannte Carbapenemase. Das sind Enzyme, die von Bakterien produziert werden und Resistenzen unter anderem gegen Reserveantibiotika aus der Gruppe der Carbapeneme verursachen. Insgesamt waren es 2533 solcher Fälle (2016: 2262).
Bei betroffenen Patienten fallen damit die meisten sehr gut wirksamen Antibiotika aus, Ärzte müssten auf die «Reserve der Reserve» zurückgreifen, sagte der Biologe Niels Pfennigwerth vom NRZ. Diese Medikamente hätten oft Nachteile wie Nebenwirkungen. Als besorgniserregend beschreiben die Autoren um Pfennigwerth insbesondere eine merkliche Zunahme von Keimen mit mehr als einer Carbapenemase. Die Folge: Die Therapiemöglichkeiten würden in der Regel noch weiter eingeschränkt.
Der NRZ-Bericht basiert auf gut 8000 Proben (2016: 7402) vor allem von Krankenhauspatienten, die 355 Labore in Deutschland 2017 an das NRZ schickten. Solche Abklärungen gibt es in der Regel dann, wenn bei einem Patienten mehrere Antibiotika nicht ansprechen. Bei einem wachsenden Teil von Proben geht es auch um die Frage, ob Resistenzen gegen das Reserveantibiotikum Colistin vorliegen.
Die Zunahme an Einsendungen um fast 8 Prozent sind für Niels Pfennigwerth Zeichen eines gestiegenen Bewusstseins für diese Erreger, aber ebenso Folge einer tatsächlichen Zunahme von Resistenzen. Er sprach von einer «bedenklichen Entwicklung», mahnte aber auch vor Alarmismus. «In Deutschland haben wir im Vergleich zu Italien und Griechenland noch ein niedriges Niveau.» Repräsentative Daten gebe es allerdings nicht.
Resistente Keime sind grundsätzlich nicht gefährlicher als andere und für Menschen mit intaktem Immunsystem in der Regel harmlos. Zum Problem können die Erreger jedoch für geschwächte Patienten werden, etwa auf Intensivstationen. Prinzipiell können sie zum Beispiel Harnwegsinfekte oder Lungenentzündungen hervorrufen und sind wegen ihrer Resistenzen nur schwer zu behandeln. Erreger entwickeln unter anderem deshalb Resistenzen, weil Antibiotika bei Mensch und Tier zu häufig und oft nicht zielgenau verabreicht werden.
23.07.2018 l dpa
Foto: Fotolia/jarun011